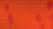

Shop locally. Shop safely. Support LOCAL businesses! SYLVANIA OCTOBER 2020 To advertise, call 419.466.7358 Japanese Steakhouse 419•517•8283 3324 Secor Rd, Toledo, OH "It’s not Just a Meal, It’s an Experience" Mon-Thur: 11:00 am - 2:30 pm 4:00 pm-9:30 pm Fri & Sat: 11:00 am - 10:30 pm Sun: 12:00 am - 9:30 pm with the purchase of $50 or more Excludes alcohol. One coupon per table. Cannot be combined with any other offer or discount. Expires 11/1/2020 FREE ORDER OF CHICKEN WINGS Dine-in Only• No Substitutions Sun- Thurs 12pm-9:30pm Friday 12pm-10:30pm Saturday 12pm-10:30pm 3535 Secor Rd. Toledo, Ohio HOURS: 10% OFF Excludes alcohol. One coupon per table Cannot be combined with any other offer or discount. Expires 11/1/2020 Dine-in Only• No Substitutions 419-851-0058


Did you know?
























































































When feeling stressed, people may want to reach for a cup of tea. Research conducted by psychologists at the City University London found that a cup of tea reduces stress, not just by drinking it, but also because of the calming effect of putting the tea kettle on. Furthermore, decaffeinated green tea also can calm a person and encourage sleep. In a 2017 study published in the journal Nutrients, participants were able to fall asleep much more easily when drinking decaffeinated green tea. Also, they reported feeling much less stressed out over the course of the one-week experiment. Even black tea has been found to relieve stress by lowering cortisol levels when a person is faced with stressful situations. According to the herbal remedy site Herbwisdom.com, chamomile tea is an age-old medicinal herb that has been used as a remedy for numerous conditions, including asthma, nervousness, sleep, and stomach ailments and as a treatment for colds. It, too, may help reduce stress. Tea has many benefits for the body, and helping to tame stress may be one of them.

When feeling stressed, you may want to reach for a cup of tea.

















Free Estimates! ROOFING • WATERPROOFING GUTTERS • SIDING • WINDOWS Senior Discounts FINANCING AS LOW AS $75 MONTH with credit approval 419-740-5192 www.SeagateFoundationServices.com LIFETIME TRANSFERABLE WARRANTY! 11 COLORS OFF 20% any whole house GUTTER HELMET Installs over existing gutters! UP TO Complete Basement WATERPROOFING $500 OFF LIFT SINKING O ver 35 Years Experience! Certain restrictions apply. Not valid with other offers. With coupon. Exp. 10/31/20 Certain restrictions apply. Not valid with other offers. With coupon. Exp. 10/31/20
EXTERIOR PAINTING POWER STAINING DECK REFINISHING INTERIOR Painting & MORE! 419-344-1811 www.frogtowncompanies.com $100 OFF PAINTED TURTLE 419-344-1811 Any $1000 Project $250 OFF PAINTED TURTLE 419-344-1811 Any $2000 Project Call Painted Turtle! With TMS Coupon. Not valid with any other offer. Expires 10/31/20 With TMS Coupon. Not valid with any other offer. Expires 10/31/20


























see menu: china1sylvania.com 20% OFF With TMS coupon. Dine-in Only. One coupon per table. Not valid with any other offer or special. Exp. 11/1/2020 Visit our Website: sylvaniadiner.com Also on Instagram 4.99 Dine-In • Call in Ordering for Carryout or Curbside Pick-Up Like us on Facebook at sylvaniadiner • 419-885-7520 Open Daily 6:30 AM to 4:00 PM Coupon Must Be Presented At Time Of Purchase Expires 10/31/20 Coupon must be presented at time of purchase only. Excludes alcoholic beverages, gift cards, postage stamps and prior purchases. No cash value/refund. Expires 10/31/20. STMS Pumpkins & Mums have arrived!
Sweet Potato Quiche
Makes 8 servings



Packed with vitamins, nutrients, fiber, and delectable flavor, sweet potatoes have earned their place on holiday dinner tables.

If you want to put a new twist on this Thanksgiving staple, whip up this recipe for “Sweet Potato Quiche”. This recipe marries sweet tubers with decadent cheese, rich cream and savory spices.
2 cups sweet potatoes, peeled and diced into small cubes
3/4 cup yellow onion, diced
21/2 tablespoons olive oil

1/2 teaspoon salt
Black pepper to taste
Egg mixture:


4 eggs
1 cup heavy cream

1/2 teaspoon fresh rosemary, minced
1/2 tablespoon fresh parsley, minced

11/2 teaspoons salt

1/4 teaspoon pepper

3 ounces Gruyere cheese, shredded Pre-baked deep dish pie crust
Preheat oven to 400 F. Mix together the first five ingredients and place on baking sheet. Roast in the oven for 15 to 20 minutes.
While sweet potatoes and onions are roasting, shred cheese and set aside. Whisk the egg mixture and set aside.
Once potatoes and onions have finished roasting, spoon them into the pre-baked pie shell. Next, layer the shredded cheese on top of the sweet potatoes.
Reduce oven to 375 F. Pour egg mixture over the cheese and potatoes. Place quiche in the oven on a center rack. Bake 20 to 25 minutes, or until eggs are set.
Take us with you. Download the NEW app today. Shop locally. Save locally. townmoneysaver.com Plus tax. Residential use only. L-shaped areas or areas exceeding 250 sq. ft. are considered 2 areas. Minimum charge $95. Cannot be used with other discounts. Coupon expires 10/31/20 Plus tax. Minimum charge $95. Cannot be used with other discounts. Coupon expires 10/31/20 Electrostatic Spraying Now Available!
























10/18/20 10/18/20 $3 OFF 3 FOR $20 Heating & Air Conditioning 419-727-1923 6226 American Rd., Tol 43612 www.ShamyHeating.com For Emergencies Call Anytime Day or Night... We Are Here For You! • Family Owned & Operated since 1981 • Honest Answers & Cost Effective Solutions • Friendly, Helpful & Knowledgeable Staff • Neat, Clean and Respectful Technicians • On-Time Arrival with Status Updates On Our 21-Point Furnace Tune Up Reg. $129 $99 Save Now! $25 OFF Any Service Repair with the Coupon Must be presented at time of service. No Expiration Date. Not valid with any other offers. Bonus Savings $1,350REBATE Get Up to a Why Choose Us for Service and Installations? OFFICE HOURS: Mon-Fri 7am-5pm SERVICE HOURS: Anytime Day or Night! • Prideful & Professional Workmanship • Highest Quality Parts & Equipment • Peace of Mind 10-Year New Installation Warranty • No-Sales Pressure, Ever! - We Treat You LIke We Would Like To Be Treated Offer expires 10/31/20 Call for details. Expires 10/31/20 with 7% Financing on a new Lennox® System.
Move over mulled ciders... this crisp



"Cranberry Margarita" makes a great autumn-inspired beverage

Cranberry Margarita
Serves 1

Oktoberfest celebrations in Germany have been held for more than 200 years, but those who can’t make it to Munich this year can still prepare these traditional recipies at home.
Spätzle
Similar to pasta and typically accompanies meat dishes. Some people may refer to it as a noodle while others call it a dumpling. Either way, it's delicious.
Maultaschen
Reminiscent of ravioli because it consists of an outer layer of dough that may be filled with various foods, including minced meat, sauerkraut or spinach. Herbs and spices, including pepper and nutmeg, add to the flavor.

Fischbrötchen
Essentially a fish sandwich, fischbrötchen is often served with Bismarck herring or soused herring, but is sometimes served with other fish, including salmon. Onions, pickles, remoulade, and/or horseradish sauce are often added.

Schweinsbraten
This is a hearty traditional Bavarian dish of roasted pork.
Rouladen












Rouladen is a meat dish that typically consists of bacon, onions, mustard, and pickles. These ingredients are wrapped together in beef or veal that is thinly sliced and then cooked together.

German cuisine is unique and flavorful and should be a part of anyone's Oktoberfest celebrations.


tequila
1 shot of cranberry juice cocktail
1/4 C of whole berry cranberry sauce
1/2 shot of triple sec



10 ice cubes
Sweetened dried cranberries, for garnish Lime, for garnish
Combine all ingredients except garnish in a blender. Blend on high until smooth and frosty. Serve in a margarita glass. Garnish with dried cranberries and a lime wheel.


20% OFF 5629 Main Street, Sylvania 419.517.4448 OPEN 7AM - 3PM EVERY DAY Minimum Purchase $5 Dine-In Only Excludes Alcohol Mon-Fri only. Max. discount $10 EXECUTIVE ON THE MAIN Not valid on holidays. Not valid with any other offer. One per table. Exp. 10/31/20 Mon-Fri 7am-11am With purchase of any beverage $449 Two Eggs Home Fries Meat & Toast Try our Delicious Homemade Soups! 1313 S Reynolds Rd, Tol (419) 389-6718 • Reynolds & Airport Hwy. 4015 Secor Rd, Tol (419) 472-1000 • Secor at W. Sylvania ® Not valid with other offers or promotions. Limit one coupon per customer per visit. Present coupon at the time of purchase. Shop retains coupon. No substitution or cash refunds. Consumer pays applicable tax. May not be reproduced, purchased, traded or sold. Internet distribution prohibited. Good at participating Toledo OH locations only. Expires 10/31/20 Buy A Double Scoop, Get A Chocolate Dipped Waffle Cone Or Bowl LIMIT 4 PER VISIT. 2 Pre-Packed Quarts $7.99 Single quart at regular price. Banana Split $5 LIMIT 4 PER VISIT. Not valid with other offers or promotions. Limit one coupon per customer per visit. Present coupon at the time of purchase. Shop retains coupon. No substitution or cash refunds. Consumer pays applicable tax. May not be reproduced, purchased, traded or sold. Internet distribution prohibited. Good at participating Toledo OH locations only. Expires 10/31/20 Not valid with other offers or promotions. Limit one coupon per customer per visit. Present coupon at the time of purchase. Shop retains coupon. No substitution or cash refunds. Consumer pays applicable tax. May not be reproduced, purchased, traded or sold. Internet distribution prohibited. Good at participating Toledo OH locations only. Expires 10/31/20 New! Creature CreationsTM Calling all creatures! No matter what kind of creature you are, we have your creation. 1 1/2 shots of


















































































Just west of Corey Rd • ElSaltoOhio.com 5817 MONROE ST SYLVANIA • 419-824-0049 $5 OFF $30 FOOD PURCHASE EXCLUDES ALCOHOL El Salto 419-824-0049 With TMS coupon. Dine-in only. Not valid other offers. Expires 10/31/20 $4 OFF TWO LUNCHEON SPECIALS EXCLUDES ALCOHOL El Salto 419-824-0049 With TMS coupon. Dine-in only. Not valid other offers. Expires 10/31/20 Carry-Out MARGARITAS still available! (with purchase of a meal) AUTHENTIC MEXICAN RESTAURANT MONDAY $1 Hard Shell Taco • TUESDAY Street Tacos (3) $7.99 WEDNESDAY 15% Off Seniors & Military • THURSDAY $3 OFF Fajitas FRIDAY/SATURDAY Margarita Specials • SUNDAY Kids Eat Free (1 with each adult meal) FULL BAR! TMSS SUN 11:30AM-9PM • MON-THURS 11AM-10PM • FRI-SAT 11AM-10:30PM TMSS 15% OFF ANY FOOD PURCHASE EXCLUDES ALCOHOL • Not valid Fri & Sat El Salto 419-824-0049 With TMS coupon. Dine-in only. Not valid other offers. Expires 10/31/20 15% OFF ANY FOOD PURCHASE EXCLUDES ALCOHOL • Not valid Fri & Sat El Salto 419-824-0049 With TMS coupon. Dine-in only. Not valid other offers. Expires 10/31/20 TMSS TMSS OUR SERVICES INCLUDE: Driveways • Sidewalks • Patios Garage Floors • Porches Pool Decks • Facory Floors Call for FREE Estimates! CONCRETE LEVELING & Repair 419.601.7060 caulking • sealing • pressure washing CONCRETE LEVELING & Repair 10% OFF Concrete Leveling Must present coupon on date of service. Not valid with any other offer. Expires 10/31/20 1815 SYLVANIA AVE. • TOLEDO • 419-472-2040 AIR CONDITIONING • Central Air Conditioning • Mini-Split Air Conditioning RETAIL PARTS CENTER Appliance Parts • Air Conditioners • Boilers & Furnaces • Water Heaters FILTERS & HUMIDIFIERS • WATER HEATERS We Service All Brands Of Air Conditioners, Furnaces & Boilers Are you tired of that old furnace breaking down? A new high efficient gas furnace can save up to 40% on your gas bill. Call us today for your FREE ESTIMATE! EATING • Gas Boilers • Gas & Electric Furnaces SAVE $100 Complete Cleaning & Safety Inspection On a New Furnace or A/C SAVE $200 On a New Furnace & A/C $9900 Furnace up to $30000 UTILITY REBATE One coupon per qualified purchase. Must present coupon at time of estimate. Not valid with any other offer. Exp. 10/31/20 One coupon per qualified purchase. Must present coupon at time of estimate. Not valid with any other offer. Exp. 10/31/20 One coupon per qualified purchase. Must present coupon at time of estimate. Not valid with any other offer. Exp. 10/31/20
A Healthy Basement Is Important Now As Ever!




*Rhino Linings for short bed from $519.95



*Tonneau Cover from $399.00
*Rust proofing (regular price $429.95)


*Undercoating from $239.95
*Complete Detailing from $249.95








German Spätzle Dumplings
Traditional German dumplings. You can also mince a few pieces of bacon in a pan, and heat the cooked spaetzle in the bacon drippings (omit the butter, if preparing recipe with bacon)
INGREDIENTS
1 cup all-purpose flour
¼ cup milk
2 large eggs eggs
½ teaspoon ground nutmeg
1 pinch ground white pepper
½ teaspoon salt

1 gallon hot water
2 tablespoons butter
2 tablespoons chopped fresh parsley
DIRECTIONS
STEP 1
Mix together flour, salt, white pepper, and nutmeg. Beat eggs well, and add alternately with the milk to the dry ingredients. Mix until smooth.
STEP 2
Press dough through spaetzle maker, or a large holed sieve or metal grater.
STEP 3
Drop a few at a time into simmering liquid. Cook 5 to 8 minutes. Drain well.
STEP 4
Saute cooked Spätzle in butter or margarine. Sprinkle chopped fresh parsley on top, and serve.



Toledo Basement Repair is a member of Diversified Group LLC Free Estimates - Licensed & Insured 10% OFF MAX VALUE $500 Please present coupon at time of estimate. Not valid with other offers. Expires 10/31/20 ANY JOB! BASEMENT EGRESS WINDOWS Provide a fast and easy way to evacuate in case of an emergency! Quality Service and Construction
egress windows are easy-to-open, allowing fresh air into your basement to improve overall ventilation and increase natural light to brighten the space... and more importantly: IT’S THE LAW! www.toledobasementrepair.com Must own property. BASEMENTS & CRAWL SPACES Waterproofing Mold • Radon Lifting Bowing Walls Soil Gasses Wall Rebuilding A healthy home starts with a healthy basement or crawl space.
Our
Nutrition Facts Per Serving: 140.9 calories; protein 4.7g 9% DV; carbohydrates 16.8g 5% DV; fat 6g 9% DV; cholesterol 73mg 24% DV; sodium 268.6mg 11% DV.
GET YOUR VEHICLE GET YOUR VEHICLE WINTER READY! WINTER READY!









































419-480-9800 www.hemp4real.com "Wholesale & Retail Available From A Name You Can Trust" CBD 4 REAL We Price Match! Buy One Get One FREE On All HEMP 4 REAL Products Must present coupon. Not good with other offers or specials. Expires 11/1/2020 HEMP & CBD Locations: CBD 4 REAL 1026 N Holland-Sylvania • Toledo, Oh 43615 CBD 4 REAL Mall (kiosk #1 located by Foot Locker, kiosk #2 located by Champs) 5001 Monroe St., Suite 700 Toledo, OH 43623 Vaporworld Hemp & CBD 236 New Towne Square Dr. Toledo, Oh 43612 25% OFF Any Regular Priced Item Good at all locations Must present coupon. Not good with other offers or specials. Expires 11/1/2020 Toledo’s Largest Selection of Vape & CBD Coming to the Mall Soon! All Locations have Capsules, Full Spectrum, Vapable CBD, Vape Pens, Isolate, Pet Tinctures, Flower & Kratom
$25





Win a Gift Card to Barry Bagels













Sylvania (October 2020)


Congratulations Tina Butler!! (Maumee)


You are the winner of our September $25 gift card































How to win...


The winning entry will be drawn from correct entries received on or before OCTOBER 14, 2020








Photo copies are acceptable. Multiple entries can be mailed in same envelope. One entry per person please. Upon entry submission, winning participants automatically authorize publicaiton of their name in the following issue of Town Money Saver. Winners will be contacted via USPS Mail.










Will you be Octoberour WINNER?


Name Ph # Address MAIL TO: Town Money Saver 5758 Main St., Unit 7, Sylvania, OH 43560 Tell us a few businesses you’d like to SEE in future issues of Town Money Saver






The GREENEST Trane Dealer in Nor thwest Ohio & S outheast Michigan W W W.OHCOMFORT.COM (419) 841-3333 Call Today For A FREE Quote With TMS Coupon. Expires 11/1/ 2020 20.00 OFF $ New PCSA (Preferred Customer Ser vice Agreement) Offer expires 10-31-20 On 20 lb. BAGS OF SEED Sale valid 10/16/20 thru 10/26/20 Ask About Our DAILY SAVINGS CLUB! Offer valid 11-1-20 to 11-30-20 Lo st Prices of the Season!





























www.LeafFilter.com/15off Promo Code: 37 LIFETIME WARRANTY THE NA TION’ S GUTTER GUARD1 1-844-440-9814 CALL US TODAY FOR A FREE ESTIMATE *The leading consumer reporting agency conducted a 16 month outdoor test of gutter guards in 2010 and recognized LeafFilter as the “#1 rated professionally installed gutter guard system in America.” *For those who qualify. One coupon per household. No obligation estimate valid for 1 year. CLOG-FREE GUTTERS OR YOUR MONEY BACK GUARANTEED! YOUR ENTIRE LEAFFILTER PURCHASE* Exclusive Offer – Redeem By Phone Today! THE FIRST 50 CALLERS WILL RECEIVE AN ADDITIONAL 15% OFF YOUR ENTIRE INSTALL! **Offer valid at estimate only 10% OFF SENIOR & MILITARY DISCOUNTS FINANCING THAT FITS YOUR BUDGET! 1 1Subject to credit approval. Call for details. 5% OFF PLUS! ADDITIONALLY Certified Service BF Goodrich • Bridgestone • Continental Dunlop • Firestone • General • Goodyear Hankook • Kelly • Michelin • Pirelli Uniroyal “Doing Business with Character” 5715 W. Central Ave., Toledo OH, BallasBuickGMC.com SERVICE HOURS: MON-FRI 7:30AM-6PM • SAT 8AM-1PM Fast & Easy Scheduling Online 24/7 @ BallasBuickGMC.com We Service All Makes & Models $ 99 50 POTHOLE SPECIAL Alignment Brake Pad & Rotor Replacement $ 25 OFF Includes Front End Alignment And Tire Rotation. Most Vehicles. Some Restrictions Apply. With Coupon. 1 Coupon Per Service. Expires 10/31/20 Must present coupon when order is written. Cannot be combined with any other specials. GM Vehicles only. Plus tax & shop supplies. One per customer. Expires 10/31/20 Oil Change Special $3995 FULL SYNTHETIC OIL! FREE CAR WASH/TIRE ROTATION Includes Up To 5 Quarts of Dexus Synthetic Oil. Top Off All Fluids. All Makes & Models, Some Models May Have Price Variances. ENGINE COOLANT SYSTEM Flush & Inspection $ 189 95 Must present coupon when order is written. Cannot be combined with any other specials. Plus tax & shop supplies. One per customer. Expires 10/31/20 Includes New A/C Delco Coolant. Inspect Radiator and Heater Hoses. Thermostat, Hoses and Gaskets. On most Makes and Models. One coupon per person. Expires 10/31/20 Get a TUNE-UP now! FREE WITH SERVICE BATTERY & CHARGING SYSTEM CHECK CHECK ENGINE LIGHT SCAN • CAR WASH FREE Essential Workers









































4519 Bennett Rd. 419-470-8821 2 TOLEDO AREA SHOWROOMS Visit us to view our many options! NEW LOCATION 2503 N. Reynolds Rd. Just north of Bancroft 419-389-9950 WWW.TOLEDONEWBATH.COM Quick Drain Walk-In Tub $600 OFF We beat all Competitor’s Prices EVERYTIME! • Lifetime Warranty • New Tub Over Your Old • Interest Free Financing Full Tub/ Bath System DISCOUNTS FOR We proudly offer New Virtual & Non-Contact Estimates Available $750 OFF New SOLUTIONS TO FIT ANY BUDGET! A Safe, Sanitary Bathroom Is Very Important! Keeping Seniors Safe & In Their Homes Longer... Is More Important Now Than Ever With COVID-19! FREE Estimates! With TMS coupon. Some restrictions apply. Exp. 10/31/20 With TMS coupon. Some restrictions apply. Exp. 10/31/20 BAD WATER? RUST STAINS? SMELLY WATER? We Have Solutions for All your Water Problems 888-668-5088 734-269-6363 8777 Ida West Rd • Ida, MI 48140 Must present coupon. Expires 11/1/2020 Reverse Osmosis Rentals Start at $9.99/MO Our Service Dept. Is guaranteed second to none! Ask your satisfied Neighbors & Friends Established in 1996 CELEBRATING 25 YEARS OF CONTINUOUS SERVICE WWW.WATERBOYSYS.COM Is Paying $4.75 For 5 Gal of Safe Bottled Water Worth it to You and Your Family? NOTICE: CITY WATER USERS Most city water customers resent the obvious chlorine smell, taste, plus the contaminates. We have the right equipment & Personnel to treat your water. • Removes Unpleasant Taste & Odor • Unwanted Chemicals • Total Dissolved Solids • Eliminates Lead SYSTEMS WE SPECIALIZE IN: ~Demand Water Softeners ~Drinking Water ~Sulfur & Iron ~Bottle Water ~Ultra Violet Whole House ~Air Puri cation (Whole House to One Room)

























































































$2650 Normal installation to existing electrical, ductwork and drain. SHREK HEAING & A/C • 419-410-3830 With TMS coupon. Exp. 10/31/20 SHREK HEAING & A/C • 419-410-3830 With TMS coupon. Exp. 10/31/20 FURNACE CLEAN & CHECK SHREK HEAING & A/C • 419-410-3830 With TMS coupon. Exp. 10/31/20 SHREK HEAING & A/C • 419-410-3830 Exp. 10/31/20 FREE SERVICE CALL WITH PAID REPAIR $99 VALUE! $95000 WATER HEATER INSTALLED 40 Gallon Natural Gas/ Standard Vent Ohio License #48537 FURNACE $7900 We keep you comfortable in Every Season! INSTALLED BRANDS MAY VARY 96% Efficient Up to 60,000 BTU EMC Blower shrekheatingtoledo.com Good Guys! Good Prices! 10% off All services forFrontline Workers 419-410-3830 shrekheating@gmail.com FREE ESTIMATES Residential Heating & Cooling Specialists • Power Washing • Sealing www.hiteconcrete.com Ask about our NEIGHBORHOOD referral discount! Licensed & Insured. Locally owned & operated - Serving Ohio, Michigan & Indiana 10% OFF Any Concrete Leveling Job! OF $200 OR MORE! Must present coupon at time of acceptance. Expires 10/31/20 419-875-4279 1-866-404-4483









































COMMERCIAL • RESIDENTIAL SERVING NORTHWEST OHIO www.BudgetDumpstersToledo.com OPEN 8:00AM-5:00PM 419-690-9896 B udgetDumpstersToledo 3307 North Holland-Sylvania Suite16, Toledo

419-740-5191 WindowWorldToledo.com VISIT OUR SHOWROOM 562 South Reynolds Rd., Toledo Mon-Fri 9am-5pm • Sat 9am-1pm Where Quality And Value Matter Most FOUR PREMIUM WINDOWS AND PATIO DOOR $89 MO. / 60 MO. *WHITE DOUBLE HUNG WINDOWS IN ANY SIZE UP TO 4’ X 6’, STANDARD 6’ PATIO DOOR WITH SOLARZONE™ GLASS PACKAGE. 60 MONTH FINANCING AT 9.99% APR WITH APPROVED CREDIT. EXTERIOR TRIM ADDITIONAL ON WINDOWS IF NEEDED. SEE STORE FOR DETAILS.
Guess Who?



























I am an actress born in New York on December 4, 1964. My breakout role in a film about a floundering attorney stuck in rural America won me an Academy Award. I've had many other film credits, including playing an aunt to a popular web-slinging superhero.









HEATING & COOLING 1 YEAR MONEY BACK GUARANTEE Inquire for details 24 MONTHS INTEREST FREE FREE Apirlaire Whole House Humidifier w/ each 96V Furnace Installed With TMS coupon. Not valid with other offers. Expires 10/31/20 FREE Safety Inspection With Furnace Cleaning $99.99 With TMS coupon. Not valid with other offers. Expires 10/31/20 419-210-8713 734-587-3184 ARE YOU FEELIN’ IT ? 5226 Monroe St • 419-843-4472 ROHR FISH INC. Complete Line Of Fresh & Saltwater Fish, Seafood & Fresh Prepared Specialities! Try Rohr’s Homemade “Heat & Serve” SEAFOOD SENSATIONS Salmon Cakes • Crab Cakes Lobster Dip • Shrimp Dip SOUPS Clam Chowder • Seafood Chowder ROHR FISH INC. ROHR FISH INC. $2 OFF Any purchase of $10 or more HOURS: Mon-Fri 9:30-5, Sat 9:30-4, Closed Sun Not valid with other offers. Expires 10/31/20 Shrimp Lovers Paradise! $1 OFF every pound of shrimp Not valid with other offers. Expires 10/31/20 Large Variety • No Limit TOLEDO’S #1 GOURMET SEAFOOD COMPANY Order your Shrimptoday!Trays COMPLETE MAKE-OVER TODAY! Paint Protection Let Us Sanitize Your Vehicles Make us your first stop for your AUTO PROTECTION! • Window Tinting • Undercoating • Rust Proofing 10% OFF PRESENT THIS COUPON FOR TST Appearance With TMS coupon. Not valid other offers. Expires 10/31/20
Answer: Marisa Tomei










































































HOURS: Mon-Thurs 10-6 • Fri 10-4 • Sat 10-2 vinyl plank carpet laminate wood vinyl 8190 LEWIS AVE. 734.847.1198 Corner of Lewis & Dean, Temperance www.cartercarpet.com CARPET .99¢ - $2.29 sq. ft. Several In Stock Colors & Styles To Choose From LAMINATE $2.99 sq. ft. Several Colors To Choose From 10% OFF MATERIAL With TMS coupon. Not valid with other offers. Exp.10/31/20 MATERIAL ONLY. Offer does not apply to in-stock material or previously placed orders. With TMS coupon. Not valid with other offers. Exp. 10/31/20 LVP $2.99 sq. ft. Several Colors To Choose From Luxury Vinyl Plank With TMS coupon. Not valid with other offers. Exp.10/31/20 With TMS coupon. Not valid with other offers. Exp.10/31/20 Proudly Offering Military/Veteran Discounts REMNANTS & ROLL ENDS .99¢ sq. ft. 12 Months Same As Cash! Professional Installation you can trust Locally owned & operated for over 30 years














































































































































































































In the SPIRIT OF HALLOWEEN, e’re TREATING our customers to The SWEETEST discounts possible... 3.9% NO PAYMENTS FOR 90 DAYS! With Approved Credit RIGHT CAR • RIGHT PRICE • RIGHT NOW! With financing AS LOW AS MANAGER’S SPECIAL TREATS! Covid-19 ASSISTANCE The Right Car at the Right Price... Right Now! TOYOTA PRE - OWNED OVER 250 CARS/TRUCKS TO CHOOSE! WE’LL PAY TOP DOLLAR & MORE FOR YOUR TRADE! 6123 W. Central, Toledo 419-841-6681 OPEN 24/7: JimWhiteToyota.com TOYOTA Let’s Go Places JIM WHITE TOYOTA BEST TREATS! 2017 HONDA CIVIC LX $16,200 2017 KIA FORTE LX $12,800 2017 CHEVY EXPRESS PASSENGER VAN $19,000 We TREAT YOU Right! STK# 20060291 STK# 20060541 STK# 206626 ’10 MITSUBISHI LANCER ES #21060701 $5,995 ’09 TOYOTA HIGHLANDER SPORT #20058941 $8,995 ’10 TOYOTA SIENNA XLE #20058941 $9,500 ’15 HONDA FIT LX #21059401 $9,995 ’14 JEEP PATRIOT LATITUDE #20061341 $11,995 ’16 FORD FUSION TITANIUM #20061851 $14,995 ’18 HONDA CIVIC LX 43K MILES #19045794 $16,995 ’17 TOYOTA COROLLA 28K MILES #206669 $17,995 ’12 FORD F150 SUPERCAB #20061172 $18,995 ’18 HONDA CR-V LX AWD #2065811 $21,797 ’17 JEEP GRAND CHEROKEE 4X4 #2065981 $30,500 ’16 JEEP WRANGLER JK SAHARA #206668 $32,995

In the SPIRIT OF HALLOWEEN, e’re TREATING our customers to The SWEETEST discounts possible... 3.9% NO PAYMENTS FOR 90 DAYS! With Approved Credit RIGHT CAR • RIGHT PRICE • RIGHT NOW! With financing AS LOW AS MANAGER’S SPECIAL TREATS! Covid-19 ASSISTANCE The Right Car at the Right Price... Right Now! TOYOTA PRE - OWNED OVER 250 CARS/TRUCKS TO CHOOSE! WE’LL PAY TOP DOLLAR & MORE FOR YOUR TRADE! 6123 W. Central, Toledo 419-841-6681 OPEN 24/7: JimWhiteToyota.com TOYOTA Let’s Go Places JIM WHITE TOYOTA BEST TREATS! 2017 HONDA CIVIC LX $16,200 2017 KIA FORTE LX $12,800 2017 CHEVY EXPRESS PASSENGER VAN $19,000 We TREAT YOU Right! STK# 20060291 STK# 20060541 STK# 206626 ’10 MITSUBISHI LANCER ES #21060701 $5,995 ’09 TOYOTA HIGHLANDER SPORT #20058941 $8,995 ’10 TOYOTA SIENNA XLE #20058941 $9,500 ’15 HONDA FIT LX #21059401 $9,995 ’14 JEEP PATRIOT LATITUDE #20061341 $11,995 ’16 FORD FUSION TITANIUM #20061851 $14,995 ’18 HONDA CIVIC LX 43K MILES #19045794 $16,995 ’17 TOYOTA COROLLA 28K MILES #206669 $17,995 ’12 FORD F150 SUPERCAB #20061172 $18,995 ’18 HONDA CR-V LX AWD #2065811 $21,797 ’17 JEEP GRAND CHEROKEE 4X4 #2065981 $30,500 ’16 JEEP WRANGLER JK SAHARA #206668 $32,995
































































































































































































































































































































































































































































































































































































































































































































































































































































